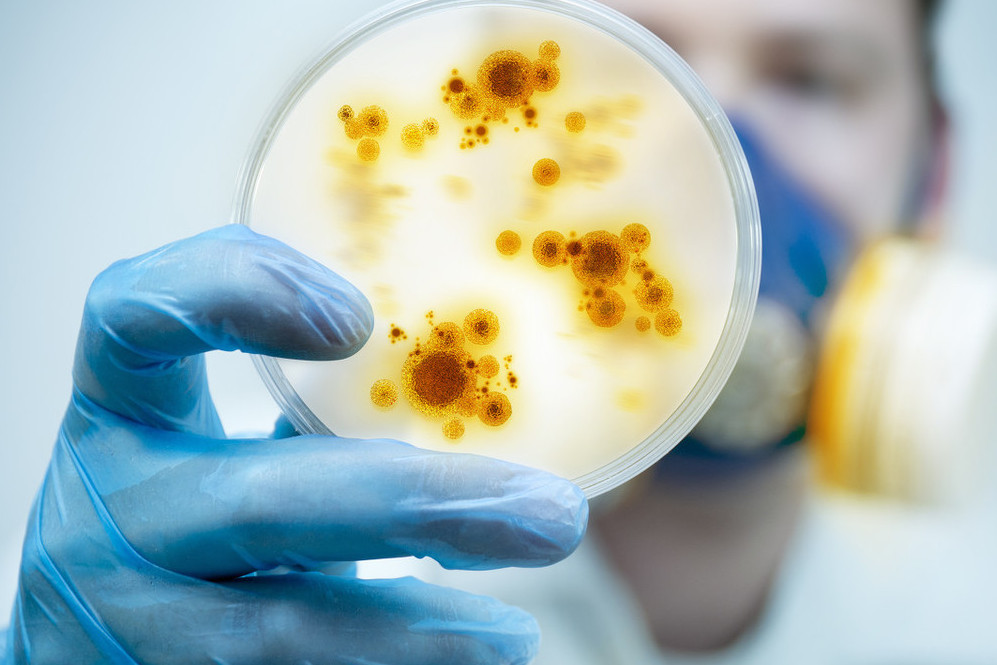
下体特别臭异味重是怎么了,下体总是有难闻的臭味怎么解决

每个人都应该注重自己的个人卫生习惯,也应该时常关注自己的身体健康,这才是对自己负责,也才是对自己身边的人负责。
尤其是对于爱美和爱干净的女孩子来说,如果出现下身有异味,这不仅是件很尴尬的事情,更严重的还是因为身体健康出现了问题,而且还会在一定程度上影响平时的生活。

请点击输入图片描述
正常来说,女性的下身味道都不是很难闻,味道也不会很大,基本是闻不到的。但是如果出现了以下的情况,那么可能会导致下身的味道比较严重,这时候就需要做出一些处理了。

请点击输入图片描述
腥臭味:这是因为女性下身的分泌物有腥臭味,主要是厌氧菌感染或者滴虫性感染而引起的一些炎症。
鱼腥味:除了由下身嗜血杆菌引起的炎症外,其他类型的妇科炎症也会出现鱼腥味的情况,同时还伴随有下身的瘙痒和疼痛,以及灼热的情况。
恶臭味:当出现这种味道的时候,一般就属于严重感染、或者妇科肿瘤病情引起的。如常见的子宫内膜炎、宫颈糜烂等妇科肿瘤疾病。
请点击输入图片描述
所以,如果女孩子下身出现了这种比较难闻的“臭味”时,除了及时上医院做妇科检查之外,日常生活中,女孩子也需要做到这些事情来改善。

请点击输入图片描述
01勤洗*裤内**
*裤内**作为紧贴下身的衣物,需要勤换勤洗,一般来说最好不要超过两天,建议就是一天一换。而且在清洗和消毒方面也需要彻底一点,这样才能减少分泌物的味道。
尽量在清洗的时候用开水烫一下,不仅能消毒,还能减少异味。

请点击输入图片描述
02每天清洗下身
女孩子由于生理结果的不同,平常的分泌物也会比较多,所以平时一定要注意下身的卫生,时常要保持清洁,尽量每天晚上用清水清洗下身、或者洗澡的时候流水清洗,这有利于减轻下身的异味。

请点击输入图片描述
03平时少用护垫
可能有些女孩子为了不经常换洗*裤内**,也或者是太爱卫生。然后为了不弄脏*裤内**,就垫上了护垫。其实这样很不好,因为经常使用护垫会导致下身潮湿,虽然吸水性好,但是不容易干。这样容易滋生大量细菌。当然大姨妈除外。

请点击输入图片描述
04*裤内**建议尽量手洗
可能有些女孩子为了偷懒,攒了一大堆的*裤内**,等到休息的时候,就用洗衣机一起洗。但是我们都知道,洗衣机平时什么样的衣物都会洗到,其中残留的细菌会比较多。这很容易引起一些妇科炎症,导致出现异味。

请点击输入图片描述
05尽量少用清洁用品清洗下身
尤其是在洗澡的时候,那些香皂、沐浴露等清洁用品,尽量别用来专门清洗下身,这样不仅会破坏下身的酸碱平衡,还可能因为皮肤脆弱引起过敏的情况。

请点击输入图片描述
结语:
这些以上个人生活中的小细节,作为女孩子,为了自己的身体健康,尽量还是需要多注意。不然自己不舒服,还可能出现很尴尬的事情。

请点击输入图片描述
今日话题:你还知道女孩子哪些日常生活中需要注意的细节,能减少异味的发生?欢迎留言评论!
声明:内容文字原创,未经授权不得转载,部分图片来源于网络,如有侵权请联系告知删除,谢谢!